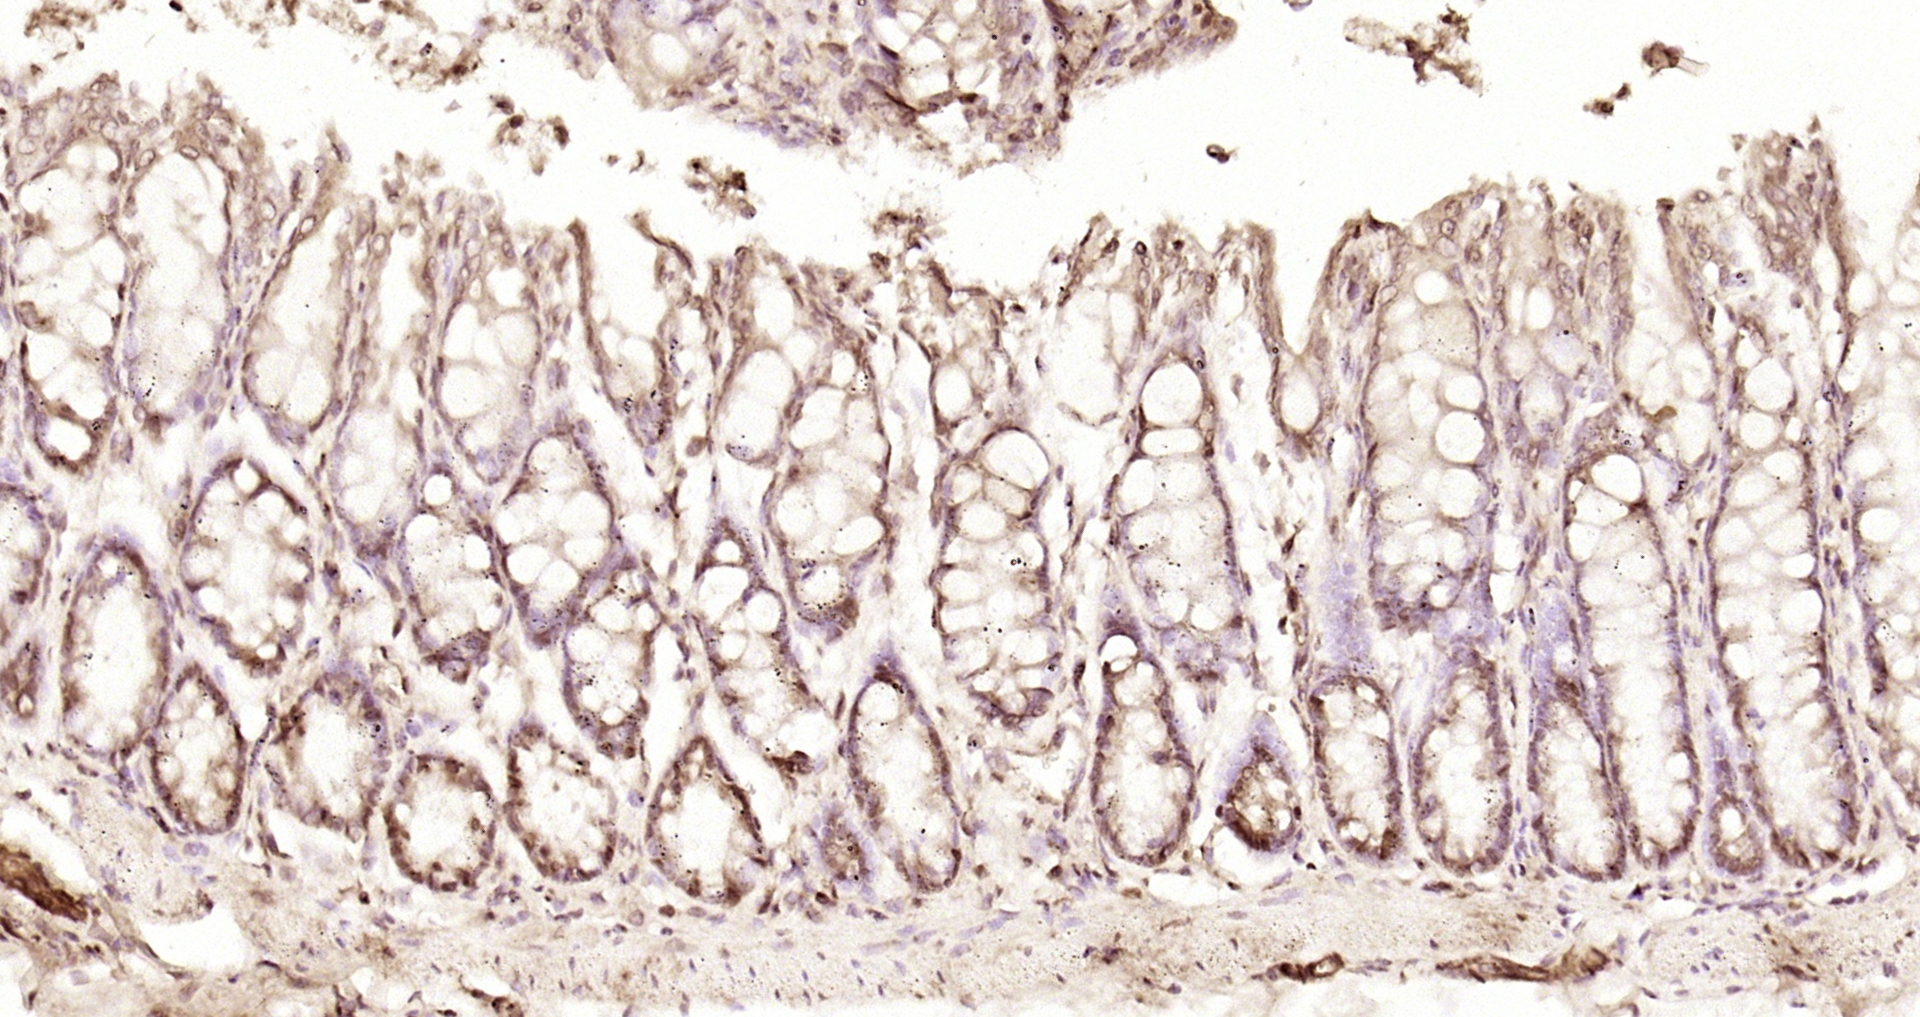
Paraformaldehyde-fixed, paraffin embedded Rat colon; Antigen retrieval by boiling in sodium citrate buffer (pH6.0) for 15min; Block endogenous peroxidase by 3% hydrogen peroxide for 20 minutes; Blocking buffer (normal goat serum) at 37°C for 30min; Antibody incubation with CLLD8 Polyclonal Antibody, Unconjugated (bs-6414R) at 1:200 overnight at 4°C, DAB staining.

Immunofluorescent staining of human cell line U-2 OS shows localization to nucleoplasm & cytosol.
Anti-SETDB2 Antibody
HPA071677
ApplicationsImmunoCytoChemistry
Product group Antibodies
ReactivityHuman
TargetSETDB2
Overview
- SupplierAtlas Antibodies
- Product NameAnti-SETDB2 Antibody
- Delivery Days Customer4
- ApplicationsImmunoCytoChemistry
- CertificationResearch Use Only
- ClonalityPolyclonal
- ConjugateUnconjugated
- Gene ID83852
- Target nameSETDB2
- Target descriptionSET domain bifurcated histone lysine methyltransferase 2
- Target synonymsC13orf4, CLLD8, CLLL8, KMT1F, histone-lysine N-methyltransferase SETDB2, SET domain bifurcated 2, chronic lymphocytic leukemia deletion region gene 8 protein, lysine N-methyltransferase 1F
- HostRabbit
- IsotypeIgG
- Protein IDQ96T68
- Protein NameHistone-lysine N-methyltransferase SETDB2
- Scientific DescriptionRecombinant Protein Epitope Signature Tag (PrEST) antigen sequence
- ReactivityHuman
- Storage Instruction-20°C,2°C to 8°C
- UNSPSC41116161

![SETDB2 antibody [N1], N-term detects SETDB2 protein at nucleus by immunofluorescent analysis. Sample: HCT 116 cells were fixed in 4% paraformaldehyde at RT for 15 min. Green: SETDB2 protein stained by SETDB2 antibody [N1], N-term (GTX108086) diluted at 1:2000. Blue: Hoechst 33342 staining.](https://www.genetex.com/upload/website/prouct_img/normal/GTX108086/GTX108086_39728_IFA_w_23060120_429.webp)